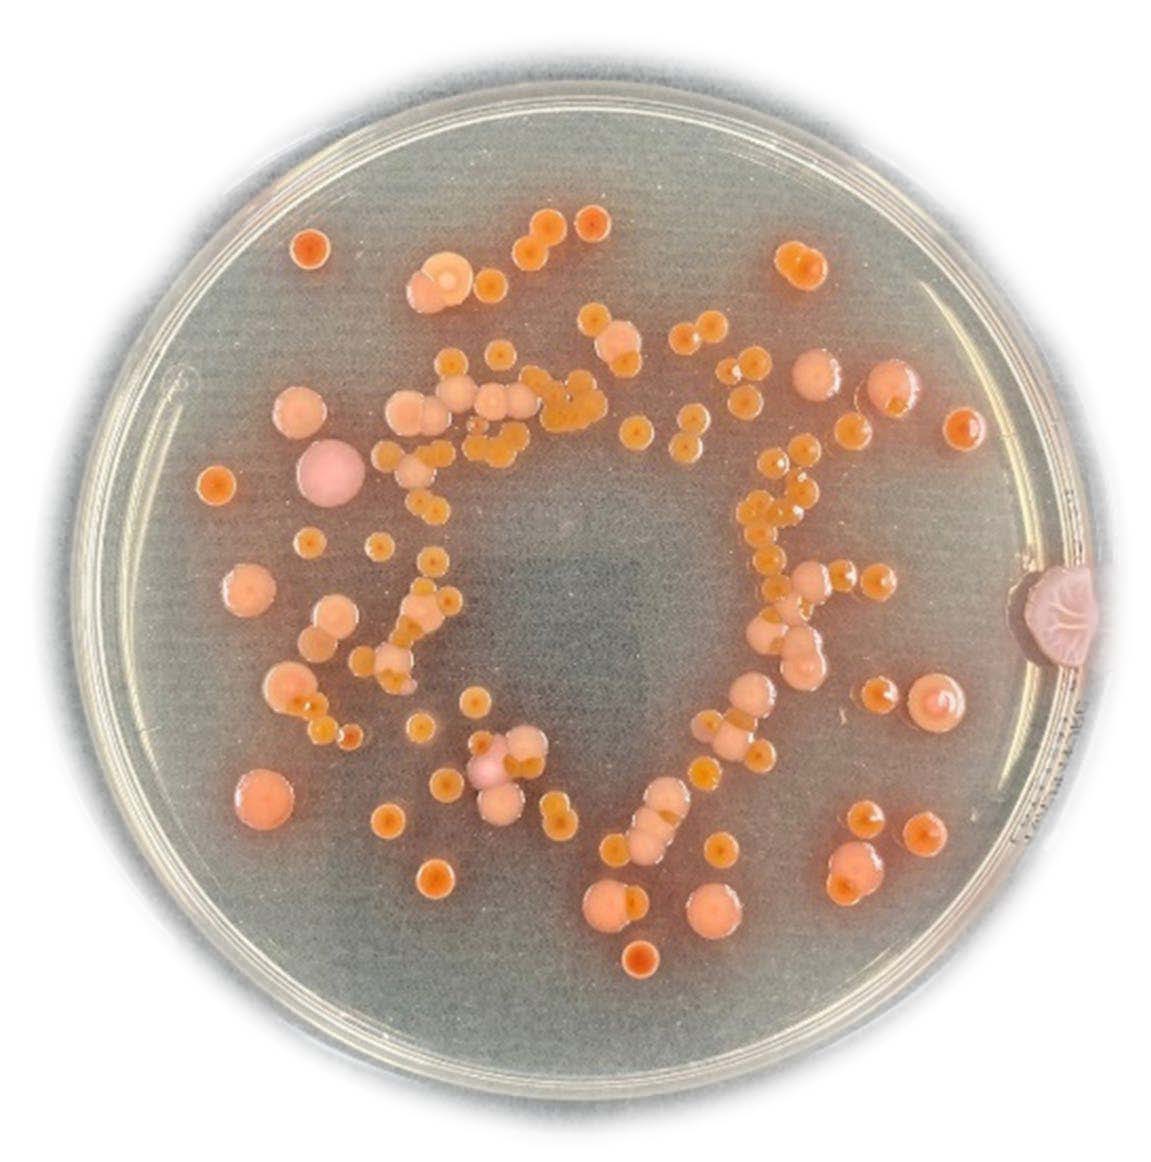
image
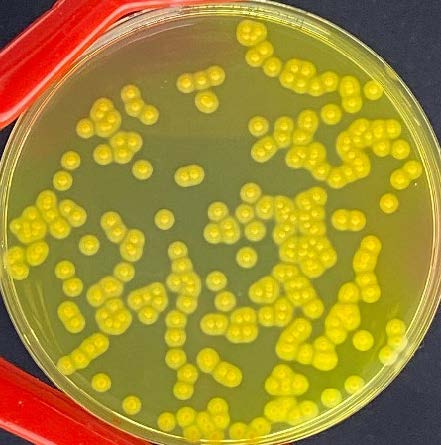
image

微生物検査消耗品
| 『Steri Water ステリウォーター』 | 『Stick Sponge スティックスポンジ』 | 『フキトレール』 |
|---|---|---|
![]() |
![]() |
![]() |
| 滅菌済みリン酸緩衝生理食塩水 ▶製品ページへ |
拭き取り検査用ツール ▶製品ページへ |
滅菌希釈液入り拭き取り検査キット ▶製品ページへ |
| 『Filter Bag Series ストマフィルター』 | 『Csc Wirebag CSCワイヤーバッグ』 | 『Anabac アナバック』 |
![]() |
![]() |
![]() |
| 滅菌済みホモジナイズバッグ ▶製品ページへ |
滅菌済みワイヤー付きバッグ ▶製品ページへ |
オートクレーブ用デオドランド ▶製品ページへ |
| 『標準寒天培地』 | 『卵黄加マンニット食塩寒天培地』 | 『ベアードパーカー寒天培地』 |
![]() |
![]() |
![]() |
| CSC培地シリーズ 一般生菌数測定用生培地 ▶製品ページへ |
CSC培地シリーズ 黄色ブドウ球菌用生培地 ▶製品ページへ |
CSC培地シリーズ 黄色ブドウ球菌用生培地 ▶製品ページへ |
お問い合わせ
フォームが表示されるまでしばらくお待ち下さい。
恐れ入りますが、しばらくお待ちいただいてもフォームが表示されない場合は、こちらまでお問い合わせください。